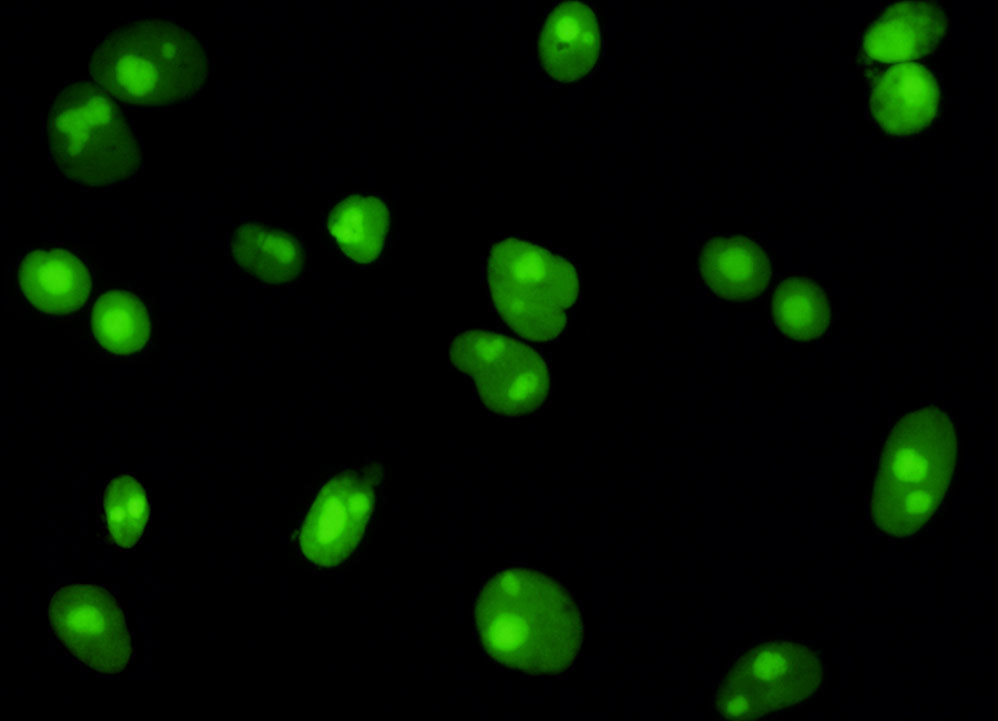

Human Fetal Lung Cell Nuclei
YFP Bandpass Emission (Narrow Bandwidth Excitation) Blue-Green Set
Fluorescence emission intensity from a culture of human fetal lung (MRC-5 line) fibroblast cells that were transfected with a pEYFP-Nucleus plasmid subcellular localization vector. Cells were transiently transfected and cultured in nutrient medium for a minimum of 24 hours before recording images. The enhanced yellow fluorescent protein gene used in these studies contains several important amino acid substitutions that shift the emission maximum of green fluorescent protein (GFP) by approximately 18 nanometers, from 509 to 527 nanometers. However, the fluorescence emission still appears green when observed in the microscope eyepieces. Note the relatively constant level of green fluorescence defining the chromatin and nuclear geometry, as well as the bright regions that correspond to nucleoli and Cajal bodies.













